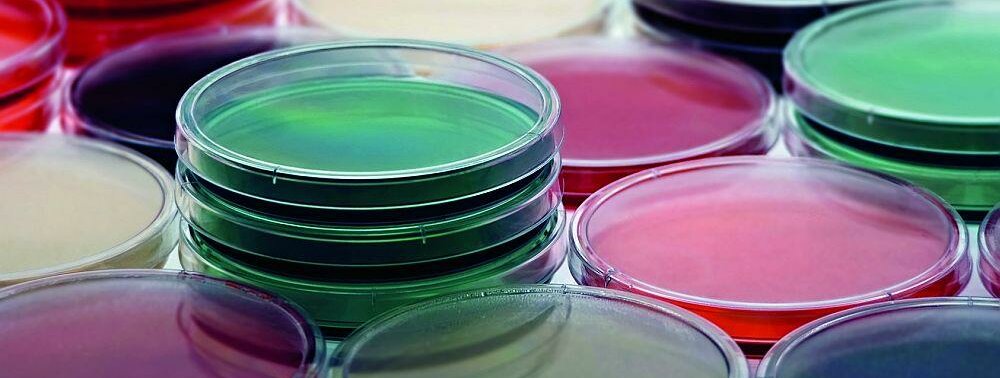

Repetitorium
BAKTERIELLE INFEKTIONSKRANKHEITEN – TEIL 1
Seite 1/1 7 Minuten
Sie sind um uns herum, auf jedem Millimeter unseres Körpers, ja sogar in ihm: Bakterien gehören zu unserer natürlichen, physiologischen Keimflora. Sie kommen auf Haut, Schleimhaut, beispielsweise in der Mundhöhle, in der Vagina, im Darm- und Urogenitaltrakt sogar in großer Menge vor. Tatsächlich beherbergt ein Erwachsener etwa 700 Gramm Bakterien im Körper und dabei mehr als 500 verschiedene Spezies. Ohne die nützlichen Winzlinge könnten wir gar nicht überleben.
Von Streptokokken und Staphylokokken auf Haut, Schleimhäuten, Lactobazillen im Vaginalbereich oder Escherichia-coli-Bakterien im Darm hat jede PTA schon einmal gehört. Leider können diese physiologischen Bakterien aber krankheitserregend wirken, wenn sie ihre ursprüngliche Körperregion verlassen und sich stattdessen an Stellen ansiedeln, wo sie vom Immunssystem schlecht abgewehrt werden können. Dies nennt sich fakultativ pathogen.
Harnwegsinfekte sind beispielsweise häufig durch einen Erregereinbruch des Darmkeims Escherichia coli bedingt. Bakteriellen Atemwegsinfekten geht häufig eine durch Viren hervorgerufene Infektion voraus, auf die sich dank Schwächung des Immunsystems dann eine durch Bakterien ausgelöste Superinfektion setzt.
»In früheren Jahrhunderten kamen durch bakterielle Infektionskrankheiten mehr Menschen ums Leben als durch Kriegseinwirkung.«
Bestimmte Krankheitserreger sind obligat pathogen, das heißt, sie machen jede ungeschützte Person krank. Diese Bakterien gehören nicht zur natürlichen Keimflora. Cholera, Diphterie, Gonorrhö, Keuchhusten, Lepra, Scharlach, Syphilis, Tuberkulose, Typhus und Paratyphus sind nur einige bekannte Beispiele. Im Gegensatz zur endogenen, also durch körpereigene Erreger ausgelösten bakteriellen Infektion, ist die exogene Infektion von außen wesentlich häufiger.
Typische Erstsymptome und Infektionswege Bakterielle Infektionskrankheiten sind übrigens der Überbegriff für alle Erkrankungen, die durch Übertragen, Haften bleiben und Eindringen von Bakterien in den Körper entstehen. Die Erreger verursachen nach Vermehrung im Körper dabei typische klinische Symptome, insbesondere Rötung (Rubor), Wärme (Calor), Schwellung (Tumor), Schmerzen (Dolor), Funktions- oder Bewegungseinschränkung (Functio laesa) sowie Fieber.
Neben Allgemeininfektionen, die den gesamten Organismus befallen, gibt es lokale bakterielle Infektionskrankheiten, bei der die Reaktion primär örtlich auf die Eintrittsstelle begrenzt bleibt, wie etwa Karies, Furunkel, Karbunkel, Otitis media. Allerdings kann es passieren, dass sich bei einer lokalen (Wund)infektion Erreger auch über das Gefäßsystem im Körper ausbreiten und den gesamten Organismus in Mitleidenschaft ziehen. Dies ist zum Beispiel bei einer Blutvergiftung (Sepsis) der Fall.
Die Erregerübertragung erfolgt ansonsten häufig über Tröpfcheninfektion (Husten, Niesen), so meist bei Scharlach, Pest, Keuchhusten, Diphterie oder Tuberkulose. Eine direkte Kontaktinfektion, etwa über Hände, Körpersäfte wie Blut, Sperma, Vaginalsekret, durch Hautverletzungen, offene Wunden in die Bakterien eindringen oder erregerhaltige Insekten, ist ebenfalls typisch. Beispiele hierfür sind Gonnorrhö oder Infektionen mit Chlamydien.
Indirekt zu den Kontaktinfektionen gehören auch die Schmierinfektionen, die beispielsweise durch Aufnahme bakterienbefallener Lebensmittel verursacht werden. Kontaminierte Eier oder Hühner übertragen häufig Salmonellen, durch verseuchtes Wasser wird Cholera übertragen. Auch Tetanus gehört zu den bakteriellen Schmierinfektionen.
Ein Problem bilden heute häufig im Krankenhaus erworbene Infekte, die nosokomialen Infektionen. Auch bei Katheterisierung oder Intubation in der häuslichen Pflege werden Patienten die Erreger eingebracht. Da dieses Klientel in der Regel über eine verminderte Immunabwehr verfügt, wiegt dies besonders schwer.
Die Verursacher des „Übels“: Bakterien Doch wer genau sind sie? Bakterien sind Mikroorganismen, genau genommen sehr kleine, einzellige Lebewesen ohne echten, klar umrissenen Zellkern. Sie sind im Durchschnitt zwischen 0,3 und 5,0 Mikrometer (μm) groß und vermehren sich in der Regel durch einfache Zweiteilung. Erstmals entdeckt wurden sie 1676 vom niederländischen Naturforscher Antoni van Leeuwenhoek mit Hilfe eines selbstgebauten Mikroskops in Gewässern und im menschlichen Speichel, was er in Berichten an die Royal Society of London beschrieb.
Grundsätzlich bestehen Bakterien aus Erbinformation: Desoxyribonucleinsäure (DNS) und Ribonukleinsäure (RNS), Plasmid(en), Ribosomen, Zytoplasma, Zytoplasmamembran und Zellwand. Die bakteriellen Zellen besitzen keinen Zellkern, stattdessen liegt das Erbgut (Desoxyribonucleinsäure, DNS) quasi „nackt” in der Zelle vor, genau genommen zusammengedrängt in einem engen Raum, dem Kernäquivalent (Nucleoid). Sie sind Prokaryoten (griech.: pro = anstatt; karyon = Kern).
Im Gegensatz dazu liegt die DNS in pflanzlichen, tierischen und menschlichen Zellen geschützt in einem Zellkern, weshalb diese zu den Eukaryoten (griech.: eu = gut, karyon = Kern) zählen. DNS-Moleküle, die nicht im Bakterienchromosom, sondern meist in Ringform geschlossen außerhalb des Nucleoids liegen, sind Plasmide. Diese enthalten viele verschiedene Gene, unter anderem auch Resistenzgene gegen Antibiotika oder Gene zur Produktion von Giften.
Ebenso gibt es Virulenzplasmide, die ein Bakterium zu einem Krankheitserreger machen. Mittels Konjugation (lat.: coniugatio = Verbindung) über Pili (Verlängerungsarme) können Plasmide zwischen Stämmen gleicher, aber auch unterschiedlicher Art schnell übertragen werden, was den raschen Austausch von genetischem Material ermöglicht. Ribosomen sind granuläre Partikel, kleine Komplexe aus Proteinen und Ribonukleinsäuren (RNS), die ebenfalls im Zytoplasma neben Boten-RNS (mRNS) vorhanden sind.
Die Umwandlung der in der mRNS gespeicherten Information in eine Abfolge von verknüpften Aminosäuren mit Hilfe der aus 50S (S = Svedberg-Einheit)- und 30S-Untereinheiten bestehenden 70S-Ribosomen wird als Translation (lat.: Übersetzung) bezeichnet und ist ein zentraler Bestandteil der Proteinbiosynthese. Das Zytoplasma selbst wird von einer Membran umgeben, die Sitz zahlreicher Enzyme ist und unter anderem den Nährstoffaustausch reguliert.
Bei den meisten Bakterien ist eine schützende Zellwand vorhanden, deren wesentlicher Bestandteil Murein, ein netzartiges Glykopolymerstützskelett ist. Dieses ist bei gram-negativen Bakterien dünn, bei gram-positiven Bakterien dick (Gramfärbung = Farbstoffmarkierung). Einige Bakterien verfügen an der Oberfläche über weitere Zusätze wie
- Kapseln und Schleime, die dem Wirtsimmunsystem die Erkennung und damit Erregerabwehr erschweren,
- Geißeln zur Fortbewegung oder
- Fimbrien zur Anheftung an Oberflächen beziehungsweise
- Pili als Art „Verlängerungsarm”.
In Struktur und Form sind Bakterien sehr unterschiedlich, wobei drei Grundformen überwiegen: Kugelförmige Bakterien (Kokken), Stäbchen- oder Schraubenförmige Bakterien. Diese treten in Paaren, Haufen oder Ketten auf. Zum Wachstum sind für die meisten Bakterien die körpertemperaturnahen Bereiche zwischen 35 und 40 °C sowie ein neutraler pH-Wert ideal.
Im sauren Milieu unterhalb pH 4 sowie im stark basischen Bereich überleben nur noch Spezialisten. Der menschliche Körper macht sich dies als Schutzmechanismus gegen krankmachende Erreger zunutze, etwa durch das saure Milieu des Magens, der Vagina oder den Säureschutzmantel der Haut. Um zu leben, benötigt die Bakterienzelle auch Nährstoffe, insbesondere sind dies Wasser, Vitamine, aber auch Mineralstoffe, wie zum Beispiel Magnesium, Eisen und diverse Spurenelemente.
Mechanismen der Krankheitsauslösung Die Pathogenität, also die Fähigkeit den gesunden Körper zu infizieren, und auch die Virulenz, also Ausmaß und Stärke der krankmachenden Eigenschaften, sind bei den einzelnen Bakterienarten sehr unterschiedlich. Fakt ist: Krankmachende Bakterien können die angeborene Immunität (Granulozyten, Komplementsystem) überwinden. Hierzu bedienen sie sich verschiedener Mechanismen, um eine Infektion auszulösen oder zu verstärken – was als Pathogenitätsfaktoren bezeichnet wird.
Dies sind Zellwandoberflächenstrukturen, wie Kapseln, Schleime, Fimbrien, Pili, aber auch Stoffwechselprodukte, wie Toxine. Letztere sind dabei zum einen Exotoxine, also komplexe Eiweiße, Enzyme, die von Bakterien produziert und freigesetzt werden und uns Menschen schädigen. So werden Diphterie, Keuchhusten (Pertussis), Scharlach und Tetanus durch Bakterienexotoxine ausgelöst.
Zum anderen gibt es Endotoxine, also Zerfallsprodukte von Bakterien, in der Regel Lipopolysaccharide der äußeren Zellmembran von gram-negativen Bakterien, welche die Freisetzung weiterer krankmachender Stoffe, wie Tumor nekrosefaktoren (TNF), Gamma-Interferonen und Interleukinen induzieren. Typhus abdominalis, eine durch bestimmte Salmonellen verursachte Infektion, ist ein Beispiel für eine Endotoxin-bedingte Infektionserkrankung. Auch Botulismus, Gasbrand und die pseudomembranöse Kolitis werden durch Bakterientoxine ausgelöst.
Daneben spielt die Möglichkeit sich intrazellulär zu vermehren, für einige Bakterienarten eine große Rolle. Listerien, Mykoplasmen, Salmonellen, die Erreger von Tuberkulose, Lepra, Typhus und der Legionärskrankheit können sich beispielsweise sowohl in Zellen eines Wirtes als auch außerhalb schnell vermehren (fakultativ intrazellulär). Chlamydien und Rickettsien vermehren sich hingegen nur in Körperzellen höherer Lebewesen, können demzufolge also nicht auf externen Nährmedien einfach angezüchtet werden (obligat intrazellulär).
Für das Immunsystem des Menschen sind Bakterien, die sich intrazellulär vermehren, nur schwer zugänglich, der Mensch kann sich also selbst nur schwer wehren. Hinzu kommt, dass es bisher nur wenige Antibiotikaklassen gibt, welche die Fähigkeit besitzen, sich intrazellulär anzureichern und die Infektion so abzuwehren. Auch Sporenbildner, insbesondere die Bakteriengattung der Bazillen und Clostridien, haben eine hohe Pathogenität. Sporen als Dauer- und Überlebensform dieser Bakterien können jahrelang unter extremen Bedingungen überleben. Sobald die Umgebungsbedingungen in punkto Feuchtigkeit und Wärme sich vorteilhaft ändern, etwa durch Infektion eines Menschen, können sich aus den Sporen wieder die vermehrungsfähigen, krankmachenden Bakterien entwickeln.
Gefürchtet: Epidemie, Pandemie In früheren Jahrhunderten kamen durch Infektionskrankheiten mehr Menschen ums Leben als durch Kriegseinwirkung. Ganze Landstriche verödeten, wenn Cholera- oder Pestepidemien wüteten. Eine Epidemie ist eine zeitlich und örtlich gehäuft auftretende Infektionskrankheit, die einen großen Teil der Bevölkerung erfasst.
Dehnt sich eine Infektionskrankheit länder- und kontinentübergreifend, also praktisch weltweit aus, wird von einer Pandemie gesprochen. Noch zu Beginn des 20. Jahrhunderts besaß eine schwere bakterielle Infektion kaum eine größere Heilungschance als derzeit ein bösartiger (maligner) Tumor. Da bakterielle Infektionskrankheiten dennoch auch heute noch lebensbedrohlich verlaufen können, sollten Betroffene immer zum unverzüglichen Arztbesuch aufgefordert werden.
Mit den richtigen Antibiotika (Chemotherapeutika) lassen sich mittlerweile die meisten bakteriell bedingten Infektionskrankheiten heilen. Während in den Industrienationen bakterielle Infektionskrankheiten somit insgesamt nur noch selten tödlich verlaufen, sterben in armen Ländern – mangels richtiger Vorsorge und ausreichen der Antibiotikaversorgung – immer noch viele Menschen daran.
Den Artikel finden Sie auch in Die PTA IN DER APOTHEKE 07/12 ab Seite 64.
Dr. Eva-Maria Stoya, Apothekerin / Journalistin